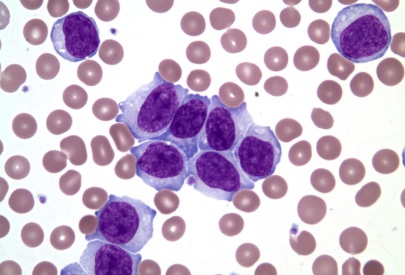
default image

Abberant Immunophenotyping in Chronic Lymphocytic Leukemia (CLL) by dr. athmar Mohammed Reda
<br />Chronic lymphocytic leukemia (CLL) is a type of cancer that primarily affects the blood and bone marrow. It involves the accumulation of abnormal, mature-appearing lymphocytes, typically B-cells, that proliferate uncontrollably. CLL is a heterogeneous disease, meaning it can vary widely in its clinical presentation and progression. One of the most important diagnostic tools for identifying CLL and assessing its characteristics is immunophenotyping. This technique is based on analyzing the surface markers or antigens present on the cells using monoclonal antibodies. Abnormalities in these markers, known as aberrant immunophenotyping, are crucial for diagnosing CLL, understanding its biology, and predicting clinical outcomes.<br /><br />Immunophenotyping in CLL Diagnosis:<br /><br />Immunophenotyping plays a vital role in confirming the diagnosis of CLL. It allows for the identification of the cellular characteristics of the leukemia cells. In CLL, the malignant cells typically express a unique combination of surface markers, most notably CD5, CD19, CD20, CD23, and sometimes CD43, that distinguish them from normal lymphocytes. However, one of the hallmarks of CLL is the occurrence of aberrant immunophenotyping, where CLL cells exhibit unusual or unexpected expression patterns of these markers, which may impact disease diagnosis and progression.<br /> <br />Aberrant Immunophenotyping Patterns in CLL:<br /><br />1. CD5 Expression on B-cells: In normal immune function, CD5 Is a surface marker typically associated with T-cells. However, in CLL, CD5 Is aberrantly expressed on malignant B-cells, a key feature that helps differentiate CLL from other forms of B-cell lymphoproliferative disorders. While this aberrant CD5 expression is characteristic of CLL, not all CLL cases display it, which can occasionally lead to diagnostic confusion.<br /><br /><br />2. CD23 Aberrancy: CD23 is another marker commonly expressed on CLL cells. Normally, CD23 is found on activated B-cells and a subset of normal B-cell lymphocytes. In CLL, CD23 is often overexpressed in the malignant cells, but aberrant expression patterns—such as weak or absent CD23—can be observed in more aggressive forms of the disease. These variations in CD23 expression can serve as a prognostic indicator, with absent or low CD23 levels often correlating with a more aggressive course.<br /><br /><br />3. Altered CD20 Expression: CD20 Is typically expressed on normal B-cells and serves as a target for certain monoclonal antibody therapies, such as rituximab. In CLL, CD20 expression Is usually weak or absent, especially in cases with more advanced or high-risk disease. This altered expression of CD20 may impact the response to immunotherapy targeting this antigen, making the study of aberrant CD20 expression crucial in treatment planning.<br /><br /><br />4. Overexpression of CD43: CD43 is anotherr antigen that can be abnormally expressed on CLL cells. It is usually absent or minimally expressed on normal B-cells but is found on CLL cells In some cases. This aberrant expression of CD43 is considered a poor prognostic factor and is often associated with high-risk disease.<br /><br /><br />5. IgM and IgD Immunoglobulin Markers: Immunoglobulin markers, specifically IgM and IgD, are critical for identifying the differentiation status of B-cells. In CLL, these markers may show aberrant patterns of expression. For instance, CLL cells may fail to express IgD properly, or their expression of IgM may be irregular. These immunoglobulin abnormalities can provide further insight into the stage and type of CLL, as well as potential resistance to certain therapies.<br /><br /><br /><br />Clinical Relevance of Aberrant Immunophenotyping:<br /><br />The Identification of aberrant immunophenotyping in CLL is not only important for diagnosis but also for prognostic evaluation and treatment planning. Aberrant expression of markers such as CD5, CD23, and CD43 is often associated with distinct clinical outcomes. For instance, high CD43 expression has been linked to aggressive disease and poor prognosis, while normal or overexpression of CD23 typically correlates with indolent forms of CLL.<br /><br />In addition, these markers help in distinguishing CLL from other B-cell malignancies, such as mantle cell lymphoma, which may exhibit similar cytological features but has a distinct immunophenotypic profile. Immunophenotyping also plays a role in predicting the response to therapy. For example, CLL cells with low or absent expression of CD20 may be less responsive to monoclonal antibody treatments like rituximab, which targets CD20.<br /><br />Genetic Implications of Aberrant Immunophenotyping:<br /><br />Along with immunophenotyping, genetic analysis is essential for understanding CLL’s biology. Certain genetic abnormalities, such as deletions on chromosomes 13q, 11q, or 17p, or mutations in TP53, are associated with a poorer prognosis. Aberrant immunophenotyping often accompanies these genetic abnormalities and may provide additional insights into the likely disease course. For instance, the presence of 17p deletions, often seen in high-risk CLL, may correlate with specific aberrations In immunophenotyping markers such as CD5 or CD23, signaling a more aggressive disease that might require more intensive treatment approaches.<br /><br />Conclusion:<br /><br />Aberrant immunophenotyping is a key feature of chronic lymphocytic leukemia (CLL) that helps define the disease and predict its clinical behavior. The identification of abnormal surface marker expression is critical for diagnosing CLL, differentiating it from other lymphoproliferative disorders, and assessing the aggressiveness of the disease. Aberrant patterns in markers like CD5, CD23, CD20, and CD43 are not only diagnostic but also carry prognostic implications that guide treatment strategies. As our understanding of CLL continues to evolve, combining aberrant immunophenotyping with genetic data will be essential for providing more personalized and effective therapeutic options for patients<br />